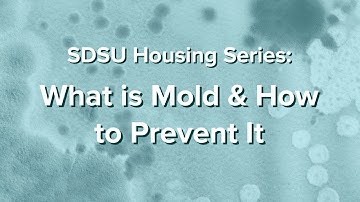
What is Mold and How to Prevent It - SDSU Housing Series: Part 1

⬇ DOWNLOAD NOW
Kalau muncul iklan pop-up, tutup lalu klik tombol kembali
Download lagu SDSU -DSCL-ME530-Spring 2023-Part 1 secara gratis hanya untuk keperluan promosi. Dukung artis favorit kamu dengan membeli musik original di iTunes atau platform resmi lainnya.
 SDSU MBB DESTROYS NAIA TEAM BY 50 - HYPE VIDEO #shorts
SDSU MBB DESTROYS NAIA TEAM BY 50 - HYPE VIDEO #shorts
 Experience driven Education at SDSU
Experience driven Education at SDSU
What is Mold and How to Prevent It - SDSU Housing Series: Part 1
What is Mold and How to Prevent It - SDSU Housing Series: Part 1
 SDSU Nursing Students 2023
SDSU Nursing Students 2023
 RYAN WILLIAMS!🤯 Georgia vs Alabama Highlights🏈 #shorts
RYAN WILLIAMS!🤯 Georgia vs Alabama Highlights🏈 #shorts
 Join SDSU's Department of Chemistry & Biochemistry
Join SDSU's Department of Chemistry & Biochemistry
 SDSU Percussion Ensemble
SDSU Percussion Ensemble
 SDSU with a slam!
SDSU with a slam!